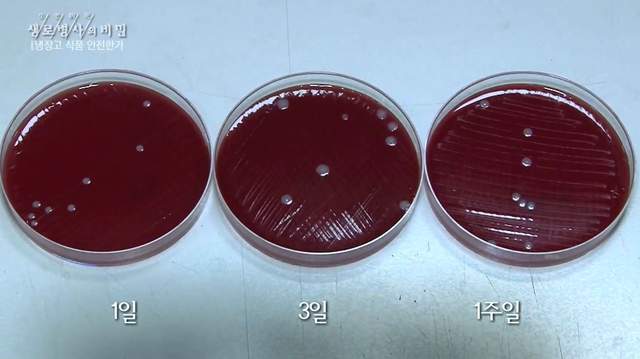
圖片8

韓國媽媽異想天開新妙方《把垃圾冰冰箱》這樣就不會有發臭了?
圖片來自:.facebook.com/kbslifesecret/videos/1045868435566052/
首先倫倫要先哀嚎自己最近都好晚睡,導致早上起來上班時都睏到爆炸阿!!有沒有早睡的秘訣誰能告訴我(哭)好抱怨完之後就要來跟大家分享最近韓綜分享的新話題啦!之前有跟大家聊過只需要一秒就可以算出《兩位數算數》結果被各種吐槽,還有不知道也不會死的《雨傘正確收法》讓倫倫以後收傘心都會驚一下w這幾天的韓綜生老病死分享了一位媽媽一直都會《把垃圾冰冰箱》的事情,到底是.....?
原汁原味的內容在這裡跟製作組分享冰箱內容物的媽媽
製作組找到這位媽媽呢,從外觀來看就是一位家庭主婦,欸斗說真的他也是一位家庭主婦啦(喂)抱歉倫倫真的太累講話都語無倫次的<( ̄︶ ̄)>
圖片來自:.facebook.com/kbslifesecret/videos/1045868435566052/
不過看似冰箱相當正常,結果這位媽媽突然從冰箱拿出了兩袋粉紅色裝著的塑膠袋,不聞味道還好,一聞發現WTF也太臭了吧!到底是!!
圖片來自:.facebook.com/kbslifesecret/videos/1045868435566052/
結果竟然是兩袋垃圾( ° ▽、° )

圖片來自:.facebook.com/kbslifesecret/videos/1045868435566052/
媽媽說「其實我也覺得不太好,但我發現如果把垃圾放冰箱的話,就不會發臭,而且也不會有蚊蟲的產生」,不過他也趕快澄清如果是吃的食物他就會用袋子包起來另外放~欸可是不都在冰箱ww

圖片來自:.facebook.com/kbslifesecret/videos/1045868435566052/
媽媽還說「以前一般來說最多可以放到兩周,不過現在覺得好像真的不太乾淨所以大概一周就會丟一次」,主要在裡面的垃圾也都是果蠅愛吃的那種水果皮啦等等的!

圖片來自:.facebook.com/kbslifesecret/videos/1045868435566052/
於是製作組就決定來看看垃圾的細菌量會因為放置的時間有沒有改變!

圖片來自:.facebook.com/kbslifesecret/videos/1045868435566052/
後來驚人的發現不管是放一天還是放三天甚至是放七天,細菌含量竟然都沒有太多改變,難道........難道以後我也要把垃圾放冰箱了嗎!!邀受哦!!
圖片來自:.facebook.com/kbslifesecret/videos/1045868435566052/
不過江東聖心醫院的醫生趕快出來表示「其實你把垃圾放冰箱只是讓細菌「凍死」,他的細菌量還是持續再生長,通通都沒有死掉喔(♡˙︶˙♡)」欸醫生是沒有用這麼俏皮的口氣啦w

圖片來自:.facebook.com/kbslifesecret/videos/1045868435566052/
所以還是要告訴卡友們,以後垃圾一定要每兩天就丟一次,垃圾桶要加蓋,隨時保持清潔知道嗎(點頭)

圖片來自:.facebook.com/kbslifesecret/videos/1045868435566052/
好不瞞大家說我也是說給我自己聽的ㄟ( ̄▽ ̄ㄟ)
部分資料來自網路 ( 음식물 쓰레기 냉동실 보관 NO )























































